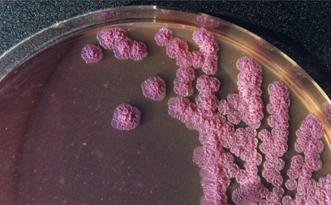

Trình bày ca bệnh
Ca bệnh thứ nhất:
Viêm hạch do vi khuẩn Burkholderia pseudomallei - là ca bệnh được báo cáo bởi nhóm tác giả Nguyễn Minh Ðường, Lê Thị Phỉ, Tô Song Diệp và Ðỗ Tấn Thức đồng tiến hành khám và điều trị, ghi nhận và báo cáo. Nhóm tác giả cho biết: Việt Nam tuy được xem là nằm trong vùng dịch tễ quan trọng của các nhiễm trùng do B. pseudomallei- kể từ khi trường hợp nhiễm bệnh được phát hiện lần đầu tại Thủ Ðức (Sài Gòn) vào năm 1925, nhưng cho đến nay chỉ có một số ít trường hợp lâm sàng được đăng tải trên các tạp chí y học trong và ngoài nước. Trước đây, tại Trung Tâm Bệnh Nhiệt Ðới cũng đã phân lập và báo cáo một số trường hợp nhiễm trùng huyết huyết nặng do B. pseudomallei, và gần đây lại tiếp tục nhận thêm một trường hợp viêm hạch bạch huyết do nhiễm tác nhân này với bệnh cảnh khá đặc trưng.
Bệnh sử: Bệnh nhân nam, 16 tuổi, làm ruộng tại Củ Chi (thành phố Hồ Chí Minh), nhập viện ngày 26/10/1999 vì sốt kéo dài và sưng hạch nách phải. Cách ngày nhập viện hai tháng, trong lúc cắt lúa ngoài ruộng bệnh nhân bị chuột đồng cắn vào ngón trỏ bàn tay phải. Sau 3-4 ngày, tại vết cắn sưng tấy, đau và tụ mủ, người có sốt nhẹ trong vài ngày. Bệnh nhân tự mua thuốc uống (không rõ loại). Sau 2 tuần, vết thương chuột cắn lành hẳn để lại dấu sẹo lồi trên ngón tay. Cách ngày nhập viện một tháng, bệnh nhân lại bị sốt kèm nổi khối sưng đỏ và đau ở nách phải. Sốt nhẹ đến vừa, thỉnh thoảng ớn lạnh hoặc run, không ảnh hưởng nhiều đến các sinh hoạt thường ngày. Sau một thời gian tự mua thuốc uống và điều trị ở nhiều phòng khám tư không thuyên giảm, bệnh nhân được giới thiệu đến khám bệnh tại Trung Tâm Bệnh Nhiệt Ðới.
Tình trạng lúc nhập viện: Tỉnh táo, người gầy sút (33,5 kg). Sốt vừa 38,5oC, mạch 105 lần/phút, HA 90/60 mmHg, nhịp thở 20 lần/phút. Vết thương chuột cắn tại ngón tay đã lành (Hình1). Hạch khuỷu tay phải sưng vừa (1x1 cm), di động, không đau. Hạch nách phải và mô mềm quanh hạch sưng to, đỏ, ấn đau, kích thước 2 x 3 cm.
Chẩn đoán ban đầu: Viêm mủ hạch nách à Bệnh nhân được nhập viện, làm các xét nghiệm thường qui, cấy máu, cấy mủ chọc hút từ hạch. Kế đó rạch rộng hạch viêm, đặt gạc dẫn lưu và điều trị ngay với cefaclor 375 mg x 2 lần/ngày.
Diễn tiến: Trong tuần lễ đầu, bệnh nhân giảm sốt nhanh. Kết quả xét nghiệm bạch cầu trong máu 9150 /mm3, bạch cầu đa nhân trung tính 67,1%. Cấy máu âm tính, cấy mủ hạch phân lập được loại trực khuẩn Gram âm ăn màu lưỡng cực và cho hình dạng khúm có nhiều nếp nhăn, gợi ý tới vi khuẩn Burkholderia pseudomallei. Trên kháng sinh đồ vi khuẩn này nhạy cảm với chloramphenicol, tetracycline và ceftazidim, trong khi đó lại đề kháng với cotrimoxazol, cefotaxim và cefaclor!
Do kết quả khảo sát vi sinh ban đầu không phù hợp với diễn tiến lâm sàng (bệnh nhân giảm sốt nhanh sau khi điều trị với cefaclor), đồng thời hình thái khúm vi khuẩn phân lập được lại thuộc loại xưa nay ít gặp trong các bệnh phẩm chọc hút từ mô hạch nên sau khi thông báo kết quả và hội ý với các bác sĩ lâm sàng, vẫn tiếp tục điều trị với cefaclor, trong khi kiểm tra lại các kết quả vi sinh.
Sau 10 ngày điều trị Cefaclor, bệnh nhân được ngưng thuốc và mau chóng bị sốt cao trở lại, áp xe hạch nách vẫn tiếp tục ra mủ (Sơ đồ 1). Kết quả định danh (với API 20NE) xác nhận vi khuẩn phân lập được là Burkholderia pseudomallei có khả năng gây bệnh (Arabinose âm tính). Chẩn đoán melioidosis thể viêm hạch mạn tính được xác lập. Bệnh nhân được đổi sang điều trị với Chloram-phenicol, liều 85mg/kg/ngày tiêm mạch chậm (3g/ngày) trong 15 ngày. Kết quả: cắt sốt sau 24 giờ, áp xe hạch hết ra mủ và liền sẹo sau 4 ngày. Bệnh nhân xuất viện, tiếp tục uống Chloramphenicol 2g/ngày và hẹn tái khám sau 7 ngày nhưng không thấy quay lại để tiếp tục theo dõi.
Sơ đồ 1: Diễn tiến lâm sàng và đáp ứng điều trị với cefaclor (750mg/ngày) và Chloramphenicol (3g/ngày)
Bàn luận: Mặc dù được phát hiện khá sớm ở Thủ đức (Sài gòn) từ cuối năm 1925 (chỉ sau Myanmar, Kuala Lumpur và Singapore), nhưng cho đến năm 1947 cũng chỉ có một số trường hợp lẻ tẻ Melioidosis xảy ra tại Việt Nam được ghi nhận trong y văn. Nguyên nhân chủ yếu có lẽ do mạng lưới chăm sóc y tế còn giới hạn, khả năng chẩn đoán vi sinh còn thiếu thốn và bệnh lý Melioidosis cũng chưa được thầy thuốc lâm sàng chưa lưu ý tới.
Bằng chứng là trong hai thời kỳ chiến tranh với Pháp (1948-1954) và Mỹ (1966-1973), trong điều kiện chăm sóc y tế được quan tâm và có sự hỗ trợ chẩn đoán về mặt vi sinh, đã có lần lượt tới khoảng 100 quân nhân Pháp và 343 quân nhân Mỹ tham chiến tại Việt Nam được phát hiện bị nhiễm bệnh.
Tuy nhiên, cũng chưa thể loại trừ các yếu tố khác như khả năng tiếp xúc thấp với nguồn bệnh và tình trạng miễn dịch tốt của cộng đồng cùng góp phần làm giảm tần suất các trường hợp mắc bệnh có biểu hiện lâm sàng.
Từ sau năm 1975 cho đến 1995, tại Trung Tâm Bệnh Nhiệt Ðới cũng không phân lập hoặc nhận được thông tin của nơi nào khác tại Việt Nam có phân lập được B. pseudomallei từ bệnh nhân Melioidosis. Tuy nhiên, cùng với sự nâng cấp cơ sở hạ tầng của phòng xét nghiệm vi sinh và nâng cao hoạt động chuyên môn của các chuyên viên vi sinh từ những năm 1992-1994, trường hợp melioidosis đầu tiên với biểu hiện huyết nhiễm tại Trung Tâm Bệnh Nhiệt Ðới đã được phát hiện vào tháng 8/ 1995 (cấy máu phân lập được tác nhân B. pseudomallei) và đến nay đã có đến 9 trường hợp huyết nhiễm nặng được xác định về lâm sàng cũng như phân lập được tác nhân gây bệnh.
Trường hợp lâm sàng được báo cáo trong bài này cũng là lần đầu tiên phát hiện melioidosis thể khu trú (viêm hạch thứ phát sau nhiễm trùng vết thương) tại Trung Tâm Bệnh Nhiệt Ðới. Hầu hết các trường hợp bệnh trong cả hai nhóm trên đều chỉ xác định được chẩn đoán và định hướng điều trị sau khi có kết quả vi sinh.
Trên phương diện lâm sàng, Melioidosis đã từng được xem là "the great mimicker" (kẻ bắt chước tài danh) do khả năng gây ra nhiều bệnh cảnh lâm sàng hết sức đa dạng với nhiều mức độ nặng nhẹ khác nhau. Ngoại trừ bệnh cảnh viêm mủ tuyến mang tai ở trẻ em tương đối đặc trưng, trong các trường hợp còn lại Melioidosis có thể biểu hiện ở nhiều dạng: cấp tính, mạn tính, tái phát, huyết nhiễm nặng, hoặc nhiễm trùng khu trú tại hầu hết các cơ quan nội tạng có hoặc không có phối hợp với nhiễm trùng máu. Cũng do tính chất gây bệnh cảnh đa dạng đi kèm với tính nhạy cảm kém với nhiều loại kháng sinh nên việc khảo sát vi sinh có vai trò rất quan trọng trong xác định chẩn đoán cũng như thiết lập phương thức điều trị hiệu quả trong bệnh Melioidosis.
Việc điều trị huyết nhiễm do B.pseudomallei cho hiệu quả khá giới hạn. Trước năm 1985 tại Thái lan, dù sử dụng phối hợp cả 4 loại kháng sinh chloramphenicol, sulfamethoxazol-trimethoprim và Doxycyclin kéo dài từ sáu tuần đến sáu tháng nhưng tỷ lệ tử vong vẫn rất cao (trên 70%).
Chỉ sau khi tiến hành nhiều nghiên cứu so sánh có đối chứng trong các năm 1988 - 1998, qua đó Ceftazidim và Amoxicillin-clavulanic acid được đưa vào sử dụng để điều trị huyết nhiễm do melioidosis thì tỷ lệ tử vong mới giảm còn chừng 40%. Trong khi đó, việc điều trị các thể nhiễm trùng khu trú do B.pseudomallei vẫn chưa có nhiều công trình khảo sát để khuyến cáo cách điều trị tối ưu.
Các phác đồ hiện tại dành cho các thể nhiễm trùng khu trú và không có triệu chứng nhiễm độc chủ yếu vẫn dựa trên kinh nghiệm và độ nhạy cảm cụ thể in vitro của tác nhân gây bệnh phân lập được. Cụ thể là có thể sử dụng một trong các kháng sinh cổ điển như chloramphenicol (40mg/kg), sulfamethoxazol-trimethoprime (20mg/kg sulfamethoxazol-4mg/kg trimetho-prim), hoặc tetracyclin (40mg/kg) từ 60 đến 150 ngày.
Phối hợp amoxycillin-clavulanic acid (30-60 mg amoxicillin /kg / ngày với cùng thời gian nói trên) cũng được- xem là có hiệu quả tốt trong điều trị melioidosis thể khu trú hoặc trong giai đoạn củng cố tiếp nối giai đoạn điều trị tấn công của các trường hợp huyết nhiễm nặng.
Ðối với các tổn thương tụ mủ ngoài phổi, có thể kéo dài liệu trình kháng sinh từ 6 tháng đến một năm tùy từng trường hợp. Trong những trường hợp cần điều trị kéo dài, đặc biệt ở trẻ em hoặc thai phụ thì phối hợp amoxycillin-clavulanic acid được dùng ưu tiên vì độc tính thấp so với các thuốc kinh điển.
Việc thu thập và báo cáo các trường hợp Melioidosis với các biểu hiện lâm sàng khác nhau một mặt tiếp tục thông tin rộng rãi đến các nhân viên y tế làm việc trong các chuyên ngành liên quan nhằm giúp làm tăng mức nhạy cảm trong việc phát hiện sớm các trường hợp Melioidosis, mặt khác là để tiếp tục bổ sung dữ liệu dịch tể về sự hiện diện của vi khuẩn B. pseudomallei - gây bệnh ở các tỉnh thành phía nam Việt Nam.
Dưới đây là một số hình ảnh minh họa cho ca bệnh ở trên
 Hình 1: Tổn thương nguyên phát: vết thương chuột cắn ở ngón trỏ bàn tay phải
|  Hình 3: Trực khuẩn Gram âm ăn màu lưỡng cực phân lập được từ mủ hạch nách.
|
 Hình 2: Áp xe hạch nách phải được rạch dẫn lưu sau khi điều trị sáu ngày với cefaclor.
| Hình 4: B. pseudomallei phân lập được từ mủ hạch trên môi trường chuyên biệt (Ashdown),
|
Ca bệnh thứ hai:
Burkholderia pseudomallei – một loại vi khuẩn có ở trong đất, xâm nhập cơ thể người qua vết da bị trầy xước và gây bệnh Melioidosis. Khi mắc bệnh này, biểu hiện lâm sàng khá phức tạp, do đó việc chẩn đoán và điều trị gặp nhiều khó khăn. Đặc biệt, tỷ lệ tử vong do Melioidosis rất cao nên nó được Chính phủ Mỹ liệt vào danh sách vũ khí sinh học tiềm năng
Bệnh sử: Bệnh nhân N.T.B. ở Ba Vì - Hà Nội, đến Bệnh viện Bạch Mai trong tình trạng sốt cao hơn 40oC, tình trạng sốt của bệnh nhân B. kéo dài từ một tháng nay và được điều trị tại địa phương mà chưa tìm được nguyên nhân gây sốt. Ban đầu, các bác sĩ chẩn đoán bà B. bị viêm phổi, nhiễm khuẩn máu. Tuy nhiên, sau 18 ngày điều trị bằng kháng sinh, tình trạng sốt cao, lúc nóng, lúc lạnh của bệnh nhân B. vẫn chưa cải thiện. Cuối cùng, các bác sĩ Khoa Truyền nhiễm - Bệnh viện Bạch Mai đã xác định nguyên nhân gây nên tình trạng sốt của bệnh nhân B. là do nhiễm một loại vi khuẩn sống trong đất có tên khoa học là Burkholderia pseudomallei (gây bệnh Melioidosis ở người). Chỉ sau 2 ngày điều trị kháng sinh đặc hiệu, các triệu chứng của bệnh nhân B. đã giảm đi rất nhiều và các cơn sốt quái ác đã hết hẳn mấy ngày sau đó. Tuy nhiên, bà B. vẫn phải tiếp tục điều trị kháng sinh tiêm liều cao trong 2 tháng, sau đó phải uống phối hợp 2 loại kháng sinh liên tục trong 6 tháng và phải được làm xét nghiệm kiểm tra định kỳ trong thời gian tiếp theo...
“Tôi chỉ làm ruộng và chăn nuôi lợn, gà chứ không có làm công việc gì khác, thế mà lại mắc bệnh này. Khi bị sốt mãi mà không tìm ra được bệnh, tôi cứ tưởng mình sẽ chết, nay được các bác sĩ ở đây tìm ra bệnh thì dù có phải điều trị mất bao nhiêu thời gian và tốn kém thế nào thì cũng phải chữa chạy cho khỏi bệnh”. - bà B. ngậm ngùi nói.
TS.BS. Phạm Thanh Thủy, Phó chủ nhiệm Khoa Truyền nhiễm - Bệnh viện Bạch Mai cho biết, bệnh Melioidosis hay còn được gọi theo tên nhà khoa học đầu tiên phát hiện ra loại vi khuẩn này là bệnh Whitmore, là một bệnh nhiễm khuẩn hiếm gặp, được BS. Whitmore phát hiện lần đầu vào những năm đầu của thế kỷ 20 ở Myanma. Còn ở Việt Nam, một trong những ca Whitmore đầu tiên được GS.Nguyễn Xuân Nguyên phát hiện trên một bệnh nhân có áp-xe ở mắt. Loại vi khuẩn này có ở đất, đặc biệt là ở vùng đất bùn bẩn, ô nhiễm.
Vi khuẩn thâm nhập vào cơ thể qua da bị trầy xước tiếp xúc trực tiếp với nước hay đất nhiễm khuẩn; hít phải bùn nước có chứa loại vi khuẩn này. Khi vi khuẩn Burkholderia pseudomallei đã thâm nhập cơ thể người, chúng có thể gây bệnh ngay hoặc “nằm yên” đến vài chục năm, chờ khi cơ thể người suy yếu là lúc thuận lợi để vi khuẩn gây bệnh, do đó bệnh thường gặp ở những bệnh nhân bị suy giảm miễn dịch, bệnh nhân đái tháo đường, suy thận...
Mỗi năm, Khoa Truyền nhiễm - Bệnh viện Bạch Mai gặp khoảng chục trường hợp mắc bệnh Melioidosis với biểu hiện lâm sàng khá phức tạp. Khi mắc căn bệnh này, triệu chứng phổ biến nhất xuất phát từ nhiễm khuẩn phổi, có thể diễn tiến từ nhẹ đến viêm phế quản, phổi nặng; cũng có thể biểu hiện khu trú bằng các ổ nhiễm khuẩn trên da.
Bệnh nhân thường có biểu hiện cấp tính như sốt cao, nhức đầu, chán ăn, ho, đau ngực và đau nhức các cơ bắp. Khi diễn biến nặng có thể gây nhiễm khuẩn máu, do đó nguy cơ tử vong cao. Khi điều trị, bệnh nhân cần được điều trị kéo dài, phải dùng kháng sinh tiêm liều cao 2 tháng, sau đó tiếp tục dùng kháng sinh ít nhất 6 tháng tiếp theo.
Điều nguy hiểm là bệnh tuy đã được điều trị nhưng lại dễ tái phát, do đó sức khỏe của bệnh nhân rất dễ suy kiệt do bệnh tái đi tái lại hoặc do điều trị không đúng phác đồ. Ngoài ra, việc điều trị bệnh phải mất nhiều thời gian và vô cùng tốn kém nên có không ít bệnh nhân không có đủ khả năng để theo điều trị. Đó là những nguyên nhân gây nên tử vong ở bệnh nhân nhiễm phải loại vi khuẩn nguy hiểm này.
Hiện nay chưa có vaccin phòng bệnh nhưng bệnh Melioidosis có thể điều trị được bằng kháng sinh nếu phát hiện sớm.
Theo Trung tâm phòng ngừa và kiểm soát dịch bệnh Mỹ thì vi khuẩn Burkholderia pseudomallei phổ biến tại khu vực Đông Nam Á và phía Bắc Australia. Bệnh phổ biến trong khu vực Việt Nam, Myanma và Malaysia. Vi khuẩn Burkholderia pseudomallei còn được Chính phủ Mỹ liệt vào danh sách vũ khí sinh học tiềm năng và còn nguy hiểm hơn virus SARS bởi tỷ lệ tử vong của bệnh cao gấp 3 lần tỷ lệ tử vong gây ra bởi SARS. Bệnh có thể nhiễm khuẩn từ da vào máu gây nhiễm khuẩn huyết hoặc diễn tiến thành một hình thái Melioidosis mạn gây thương tổn đến tim, động mạch chủ bụng, não, gan, thận, khớp và mắt...Đặc biệt là các loài động vật cừu, dê, ngựa, lợn, trâu bò, chó và mèo có thể nhiễm vi khuẩn Burkholderia pseudomallei và truyền căn bệnh tương tự sang con người. - Năm 2004, có tới 24/79 bệnh nhân nhiễm vi khuẩn Burkholderia pseudomallei tại Singapore tử vong. Số ca tử vong nhiều buộc Bộ Y tế Singapore phải tiến hành điều tra làm rõ liệu bệnh này có phải được gây ra một cách có chủ định hay không. Kết luận của các nhà điều tra là không có dấu hiệu cho thấy vi khuẩn Burkholderia pseudomallei đã từng được tạo ra bởi con người. - Từ ngày 11/7 - 1/8 năm 2005, tại Đài Loan có 19 ca mắc bệnh, trong đó 7 người thiệt mạng do viêm phổi và nhiễm khuẩn máu. Trong khi nguyên nhân gây ra đợt bộc phát chưa được xác định, cơ quan y tế Đài Loan cho rằng, cơn bão Hải Đường gây ngập lụt ở Đài Loan tháng trước đó có thể đã giúp đưa vi khuẩn nằm sâu trong đất lên bề mặt và phát tán bệnh |
Tổng hợp y văn và cập nhật thông tin về lâm sàng bệnh Melioidosis
Cơ chế bệnh sinh
B. pseudomallei là một “tác nhân tình cờ”. Đó là những sinh vật có mặt trong môi trường mà không nhất thiết nhu cầu thông qua vật chủ trung gian để sinh trưởng và nhân lên. Do các đặc điểm của vi khuẩn như thế đó, nên nhiễm bệnh ở người được xem như là điểm chết cuối cùng của sinh vật này (“dead end”). Các chủng vi khuẩn này gây bệnh ở người thì khác so với các chủng gây bệnh ở động vật nhờ vàoviệc phân tích giải mã cấu trúc gen học của vi khuẩn.
B. pseudomallei có thể xâm nhập vào trong các tế bào, tổng hợp các actin và lan rộng từ tế bào này sang tế bào khác, gây nên quá trình hợp nhất các tế bào với nhau và hình thànhcác tế bào khổng lồ đa nhân (multinucleate giant cell). B. pseudomallei là một trong những “proteobacteria” đầu tiên được xác định có chứa một hệ thống bài tiết type 6.
Vi khuẩn này còn được gọi là vi sinh vật duy nhất có khả năng chứa đến 6 hệ thống tiết độc lập với nhau. Chúng có khả năng gây bệnh ở người vì DNA nhận từ các vi sinh vật khác. Quá trình đột biến có tỷ lệ cao và vi sinh vật tiếp tục tiến triển sau khi nhiễm vào trong vật chủ.
B. pseudomallei có tính đề kháng nôi sinh với một số lượng lớn các tác nhân vi sinh vật khác. Một cơ chế quan trọng là chúng có khả năng bơm thuốc ra khỏi tế bào và điều này làm cầu nối trung gian cho kháng xảy ra với nhóm kháng sinh aminoglycosides (AmrAB - OprA), tetracyclines, fluoroquinolones và macrolides (BpeAB-OprB).
Triệu chứng lâm sàng và thể bệnh Melioidosis ở người
Bệnh Melioidosis có thể phân loại như một bệnh nhiễm trùng cấp tính hoặc tại chỗ, nhiễm trùng phổi cấp tính, nhiễm trùng toàn bộ hệ tuần hoàn và nhiễm trùng lan tỏa. Thể nhiễm trùng chưa biểu hiện lâm sàng (sub-clinical infections) cũng có thể gặp. Thời gian ủ bệnh chưa thể xác định một cách rõ ràng, nhưng có thể dao động từ vài ngày đến nhiều năm; nói chung triệu chứng dường như xuất hiện 2-4 tuần sau khi tiếp xúc hoặc phơi nhiễm với mầm bệnh.
Mặc dù người khỏe mạnh có thể mắc bệnh Melioidosis, nhưng các yếu tố nguy cơ chính là đáo tháo đường, bệnh về gan, thận, thalassemia, và/ hoặc tình trạng suy gảm miễn dichj không liên quan đến HIV. Điều quan trọng là đáng chú ý đến bệnh Melioidosis thường được gọi “Kẻ bắt chước vĩ đại” ("The Great Mimicker") vì nó có một phổ lâm sàng đa dạng về hình thái biểu hiện rất dễ nhầm lẫn với một số bệnh khác như lao, viêm phổi,...
Về các thể bệnh, chúng ta có thể chia ra các thể như sau:
Thể tại chỗ hay cấp tính khu trú (acute, localized form)
Thể bênh này nói chung là khu trú như một vết loét, nốt hoặc abces da niêm do quá trình mầm bệnh xuyên qua da vào các vết thương sẵn có. Thể cấp tính của bệnh Melioidosis có thể biểu hiện sốt và đau cơ toàn thân. Bệnh có thể biểu hiện khu trú hoặc có thể diễn tiến nhanh chóng gây nhiễm trùng huyết.
Vi khuẩn đi vào da thông qua một vết rách hoặc vết trầy xước da và nhiễm trùng tại chỗ với các vết loét tiến triển. Thời gian ủ bệnh thường 1-5 ngày. Các tuyến hạch lympho sưng, vi khuẩn đi vào vật chủ thông qua niêm mạc có thể gây các tăng tiết nhầy tại các vùng bị ảnh hưởng.
Thể phổi (Pulmonary form/ lung infection)
Khi vi khuẩn đi vào bằng đường khí dung hoặc vào đường hô hấp thông qua hít phải lan rộng và nhiễm trùng phổi lan rộng. Viêm phổi, abces phổi và tràn dịch màng phổi có thể xảy ra. Thời gian ủ bệnh khoảng 10-14 ngày. Với bệnh melioidosis do hít phải, abces da có thể phát triểnvà mất vài tháng mới xuất hiện.
Khởi bệnh của thể phổi thường điển hình đi kèm bởi sốt cao, nhức đầu, chán ăn và đau mỏi cơ toàn thân. Đau ngực là hay gặp, nhưng có ho hoặc không ho có đờm là một dấu chỉ điểm có giá trị (hallmark) của thể này. Tổn thương khoang cũng có thể nhìn thấy trên phim chup X quang phổi tương tự như hình ảnh trong lao phổi.
Thể nhiễm trùng huyết (Septicemia/ bloodstream infection)
Khi vi khuẩn phát tán và di chuyển trong dòng máu của bệnh loét mũi thú y (glanders), thường tử vong trong vòng 7-10 ngày. Nhiễm trùng huyết phát triển và ảnh hưởng đến nhiều cơ quan, da, han, lách cũng có thể ảnh hưởng nghiêm trọng.
Với bệnh Melioidosis, nhiễm khuẩn huyết được quan sát trên các bệnh nhân nhiễm trùng có bệnh mạn tính. (ví dụ bệnh nhân HIV, đái tháo đường). Chúng có thể gây suy hô hấp, nhức đầu, sốt, tiêu chảy, tổn thương cơ qua chứa đầy mủ và abces lan tràn khắp các cơ quan. Nhiễm trùng huyết có thể rất nặng, với 90% tử vong xảy ra trong vòng 24-48 giờ.
Các bệnh nhân có các yếu tố nền sẵn có như đái tháo đường và suy thận thường có xu hướng diễn tiến đến hình thái lâm sàng này và thường dẫn đến hậu quả sốc nhiễm trùng. Các triệu chứng của nhiễm trùng huyết có thể là sốt, nhức đầu, suy hô hấp, đau bụng, đau khớp, mất định hướng,…Khởi đầu các triệu chứng thường rất nhanh và khối abces có thể nhìn thấy khắp cơ thể, đáng chú ý là gan, lách và tuyến tiền liệt.
Thể nhiễm trùng lan tỏa (Disseminated infection)
Bệnh Melioidosis lan tỏa là một bệnh nhiễm trùng biểu hiện với các ổ abces hình thành tại nhiều cơ quan khác nhau trong cơ thể. Có thể hoặc không liên quan đến nhiễm trùng. Các cơ quan liên quan thường điển hình là gan, phổi, lách và tuyến tiền liệt; liên quan đến các khớp, xương, phủ tạng, hệ lympho, da và não cũng có thể xảy ra.
Nhiễm trùng lan tỏa có thể nhìn thấy trong bệnh Melioidosis cấp và mạn tính. Các dấu chứng và triệu chứng còn có sốt, sụt cân, đau ngực, đau dạ dày, đau cơ, bắp thịt, nhức đầu và co giật.
Thể mạn tính (Chronic form)
Thể mạn tính liên quan đến đa ổ abces và ảnh hưởng đến nhiều cơ quan gan, lách, da, cơ. Thể này cũng được biết là bệnh lở ngứa ở ngựa và có thể tái hoạt nhiều năm sau khi nhiễm trùng tiên phát.
Chẩn đoán và điều trị
Chẩn đoán bệnh Melioidosis được đánh giá thông qua soi kính hiển vi của các bệnh phẩm máu, nước tiểu, đờm hoặc mẫu da tại phòng xét nghiệm. Một xét nghiệm máu rất có ích để phát hiện sớm các trường hợp cấp tính của bệnh Melioidosis, nhưng không thể loại trừ bệnh nếu xét nghiệm âm tính. Các xét nghiệm thường dùng là: xét nghiệm kết dính hồng cầu gián tiếp (indirect hemagglutination_IHA), xét nghiệm cố định bổ thể (complement fixation_CF) và phản ứng chuỗi trùng hợp (Polymerase chain reaction_PCR).
Hình thái học của vi khuẩn Burkholderia pseudomallei
Vi khuẩn Burkholderia pseudomallei còn có tên gọi khác là Pseudomonas pseudomallei, đây làvi khuẩn gram âm, lưỡng cực, hiếu khí, hình roi, di động. Nó nhiễm lên con người và cả động vật và là nguyên nhân gây bệnh Melioidosis. Nó cũng có thể ảnh hưởng hoặc gây bệnh đến các loại thực vật.
B. pseudomallei có chiều dài khoảng từ 2-5 μm và đường kínhtừ 0.4-0.8 μm và cũng có thể sử dụng roi để di chuyển theo hướng tới. Vi khuẩn có thể tăng trưởng bằng chất dinh dưỡng trong một số môi trường nhân tạo, đặc biệt là môi trường chứa nhóm đường betaine và acid amine arginine. Trong nuôi cấy in vitro, nhiệt độ tối ưu cho sự tăng trưởng nhanh của vi khuẩn là khoảng 40°C trong điều kiện pH môi trường trung tính hoặc acid yếu khoảng (pH = 6.8-7.0).
Đa số các chủng này có khả năng lên men với đường không sinh hơi (quan trọng nhất là đường glucose và galactose, việc nuôi cấy trước đây thì cũng chuyển hóa thành đường maltose và tinh bột). Vi khuẩn này sản sinh ra cả nội độc tố và ngoại độc tố. Vai trò của các độc tố này được xác định trong quá trình hình thành triệu chứng của bệnh Melioidosis nhưng vẫn chưa được làm sáng tỏ.
Định loại và chẩn đoán
B. pseudomalleităng trưởng được trong các môi trường nuôi cấy đa dạng (thạch máu, thạch Mac Conkey, EMB,…). Môi trường nuôi cấy Ashdown (hoặc môi trường nuôi cấy Burkholderia cepacia) có thể được sử dụng để lựa chọn nuôi cấy đặc hiệu. Các mẻ nuôi cấy chủng chuyển dương tính trong 24 đến 48 giờ (dựa vào đặc tính tốc độ phát triển nhanh này người ta dùng để phân biệt với các vi khuẩn từ B. mallei - là các chủng phải cần ít nhất 72 giờ mới phát triển).
Đặc điểm khúm vi khuẩn là có nếp nhăn, xuất hiện ánh kim và có mùi đất hoặc mùi rễ cây (earthy odour). Nhuộm gram cho kết quả là trực khuẩn gram âm với đặc trưng ở hai đầu vi khuẩn có dạng vòng. Trong kiểm tra tính nhạy, hình như vi khuẩn biểu hiện khả năng kháng cao (kháng hoàn toàn với các thuốc kháng sinh, bao gồm cả loại colistin và gentamicin) và đó là đặc điểm để phân biệt với B. mallei - nó thì ngược lại nhạy một cách không rõ ràng với một số lượng lớn kháng sinh. Chỉ có những mẫu bệnh phẩm lấy từ trong môi trường, sự phân biệt với các chủng B. thailandensis không gây bệnh dựa vào thử nghiệm Arabinose là cần thiết (B. thailandensis không bao giờ được phân lập từ các mẫu bệnh phẩm lâm sàng).
Việc định loại vi khuẩn B. pseudomallei trong điều kiện phòng thí nghiệm có thể gặp khó khăn, đặc biệt là ở các quốc gia phương tây, nơi mà vi khuẩn B. pseudomallei rất hiếm nhìn thấy. Những khúm vi khuẩn có nếp nhăn lớn trông giống như là những chất gây nhiễm có trong môi trường và vì thế chúng thường bị loại bỏ và không có ý nghĩa lâm sàng.
Vi khuẩn này phát triển chậm hơn các vi khuẩn khác mà chúng cùng hiện diện trên cùng bệnh phẩm lâm sàng và trên những bệnh phẩm thu thập được từ những vị trí không vô trùng, thì vi khuẩn rất dễ phát triển tràn lan. Vì vậy, những mẫu bệnh phẩm lấy từ vùng không vô trùng nên được nuôi cấy trong môi trường chọn lọc (ví dụ như môi trường Ashdown hoặc môi trường dành cho nuôi cấy B. cepacia.
Chỉ khi việc phân lập được xem như là có ý nghĩa, thường phương pháp nhận định vi khuẩn được sử dụng có thể nhận dạng sai vi khuẩn với một số khác như Chromobacterium violaceum hoặc nhóm vi khuẩn gram âm không lên men khác như Burkholderia cepacia hoặc Pseudomonas aeruginosa. Ngược lại, bởi vì bệnh này hiếm thấy các khu vực các nước phương Tây, nên việc nhận dạng vi khuẩn B. pseudomallei trong môi trường nuôi cấy chưa thực sự coi trọng như tiếng chuông cảnh báo cho các bác sĩ chưa quen với bệnh này.
Các phương pháp sinh hóa thường quy để định loại vi khuẩn khác nhau nhiều: hệ thống API 20NE nhận dạng một cách chính xác B. pseudomallei trong 99% số ca, đây cũng là hệ thống tự động Vitek 1, nhưng phương pháp định loại tự động Vitek 2 chỉ nhận diện 19% trong tổng số ca được phân lập. Bệnh Melioidosis được chẩn đoán nhờ vào phân lập vi khuẩn Burkholderia pseudomallei từ máu, nước tiểu, đờm, vết thương ở da hoặc từ các tạng bị abces. Phát hiện và đo nồng độ kháng thể (Ab) chống lại vi khuẩn trong máu cũng rất hữu ích.
Một số xét nghiệm khác cũng góp phần không nhỏ vào trong xác định bệnh và các biến chứng đi kèm trong bệnh Melioidosis là công thức máu toàn phần, sinhhóa máu và nước tiểu về gan thận, tim mạch. Chụp X-quang phổi và điện tâm đồ, điện cơ là cần thiết trong những ca quá nặng đa biến chứng. Mô hình kháng thuốc với các thuốc diệt vi khuẩn thì được phân định rõ ràng và giúp để phân biệt các vi khuẩn với trực khuẩn mủ xanh P. aeruginosa.
Đa số các phân lập của B. pseudomallei thì kháng nội tại với tất cả thuốc kháng sinh nhóm aminoglycosides (thông qua cơ cơ chế bơm đẩy, nhưng lại nhạycảm với kháng sinh co-amoxiclav: mô hình kháng này hầu như chưa bao giờ xảy ra đối với vi khuẩn P. aeruginosa và điều này rất có ích trong việc định loại vi khuẩn.
Chẩn đoán bằng kỹ thuật PCR có thể thực hiện được, nhưng không thể làm thường quy trong chẩn đoán lâm sàng. Tại Thái Lan, phản ứng ngưng kết hạt latex được dùng rộng rãi để chẩn đoán. Kỹ thuật miễn dịch huỳnh quang phát hiện kháng thể cũng có giá trị và đang có sẵn trong một số ít trung tâm ở Thái Lan.
Thái độ xử trí
Hầu hết các trường hợp Melioidosis có thể điều trị thành công bằng liệu pháp điều trị ký sinh trùng thích hợp;
Burkholderia pseudomallei, loài vi khuẩn gây bệnh Melioidosis thường nhạy với các thuốc Ceftazidime, Imipenem, Meropenem, Doxycycline, Trimethoprim/sulfamethoxazole, Piperacillin, Amoxicillin-clavulanic acid, Azlocillin, Ticarcillin-clavulanate, Ceftriaxone, Aztreonam.
-Điều trị nên bắt đầu sớm khi phát hiện ra bệnh vì bệnh Melioidosis có thể tiến triển ra các thể nặng hơn và thậm chí có thể tử vong, lệ thuộc vào nhiều yếu tố nguy cơ ảnh hưởng lên khả năng tự cơ thể chống lại bệnh này.
-Loại nhiễm trùng và liệu trình điều trị sẽ tác động lên kết quả điều trị về lâu dài. Nói chung, điều trị nên bắt đầu sớm với liệu pháp kháng sinh truyền tĩnh mạch trong vòng 10-14 ngày, và theo sau là liệu pháp đường uống 3-6 tháng.
-Việc điều trị bệnh Melioidosis liên quan đến các kháng sinh và lệ thuộc vào vị trí thương tổn cũng như từng thể của bệnh.
-Đối với các bệnh nhân bệnh biểu hiện nhẹ, Trung tâm Phòng chống bệnh CDC Mỹ khuyên dùng kháng sinh: Imipenem, Penicillin, Doxycycline, Amoxicillin - Clavulanic acid, Ceftazidime, Ticarcillin-clavulanic acid, Ceftriaxone, Aztreonam.
-Các bênh nhân bị nặng, nghiêm trọng thì dùng thuốc phối hợp từ 2 đến 12 tháng.
-Với các thể liên quan đến phổi của bệnh Melioidosis, nếu nuôi cấy vẫn còn dương tính trong 6 tháng, đề nghị phẩu thuật loại bỏ khối abces phổi thông qua cắt thùy phổi.
Các khuyến cáo điều trị bệnh Melioidosis
Điều trị cấp cứu tích cực ban đầu (kéo dài ≥ 14 ngày) HOẶC |
Ceftazidime | 50mg/kg đến 2g | Mỗi 6 giờ |
Meropenem | 25mg/ kg đến 1g | Mỗi 8 giờ |
Imipenem | 25mg/kg đến 1g | Mỗi 6 giờ |
Trimethprime - Sulfamethoxazole | 8 + 40mg/kg đến 320 + 1600mg/kg | Mỗi 12 giờ |
Điều trị loại bỏ/ tiệt căn (kéo dài ≥ 3 tháng) VÀ LỰA CHỌN TỐI ƯU |
Trimethprime - Sulfamethoxazole | 8 + 40mg/kg đến 320 + 1600mg/kg | Mỗi 12 giờ |
Doxycycline | 2mg/kg đến 100mg | Mỗi 12 giờ |